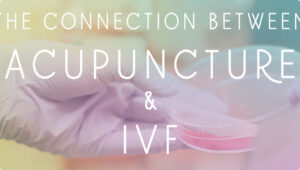
Improving-IVF-Success-Rates-Through-Acupuncture

Improving IVF Success Rates Through Acupuncture
Whatever your reasons for electing to try IVF (In Vitro Fertilization), you probably didn’t start out with visions of blood tests, ultrasounds, and daily self-administered shots as part of your future child’s conception story. Most couples don’t arrive at IVF until they exhausted all other options after years of grappling
